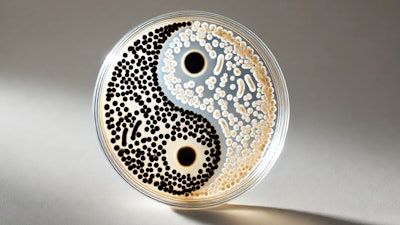
Dall·e 2024 10 28 15 31 36 A Close Up Image Of A Petri Dish With A Yin Yang Symbol Inside, Made From Colonies Of Light And Dark Bifidobacterium Bacteria The Bacteria Form Disti

Although probiotics have grown in popularity in pet food and treats, keeping the microbes alive can challenge pet food processors. Probiotics are living bacteria and other organisms that both people and pets consume for health benefits, especially related to digestion. The high temperatures reached during the making of pet food may kill off these probiotics. However, once a probiotic passes away, it may still have benefits as a postbiotic. In a study on the bacteria Bifidobacterium animalis, both the living and the dead forms had beneficial effects on dogs’ health.
“The popularity of functional ingredients has increased as pet owners seek ways to improve the health and wellness of their pets, yet limited research has been conducted regarding the use of probiotics and postbiotics and their effects on canine health,” Sophie Nixon, Ph.D., head of clinical research for pet and animal well-being at ADM, who oversaw the trial, said in a press release. The variety of bacteria used in the study, Bifidobacterium animalis subsp. lactis CECT 8145 (BPL1), is produced by ADM. The Journal of Animal Science published the results of the study.
Experiment comparing prebiotics to postbiotics
For this exploratory study, 18 adult beagles and 18 adult English pointers were used in a randomized, placebo-controlled, parallel group design, with 12 animals per group. Following a 60-day adaptation period in which dogs were fed a standard diet alone, the dogs were then supplemented with either probiotic or postbiotic BPL1™ or an identical placebo alongside their standard diet for 90 days. Measurements were taken to assess outcome measures relating to a variety of health areas, including fecal fermentative end products and microbiome, insulin sensitivity, serum gut hormones, oxidative stress, inflammatory biomarkers and white blood cell gene expression.
Improvements were observed in fecal short-chain fatty acids, as well as changes in microbiome composition and the functional metagenome, when compared to placebo control. Data from the trial shows that both the live and heat-treated forms of BPL1™ can safely be supplemented in healthy adult dogs and support several aspects of gut health. A further clinical study is ongoing to assess additional physiological outcomes, with a focus on metabolic health.
1. Fecal Health Outcomes
- Fecal scores remained consistent across all groups, indicating that neither probiotics nor postbiotics negatively impacted stool quality.
- Dogs receiving the postbiotic exhibited a significantly lower fecal pH compared to the control group. Lower fecal pH is often associated with improved gut health, as it suggests a more favorable environment for beneficial bacteria.
- Both PRO and POST supplementation increased fecal propionate concentrations, a short-chain fatty acid linked to various health benefits, including anti-inflammatory properties.
2. Microbiome Composition and Functionality
- Probiotic and postbiotic supplementation altered bacterial composition at the family and genus levels, though overall richness and diversity remained unaffected.
- Functional analysis indicated potentially beneficial changes in metabolic pathways, including those related to pathogenicity, amino acid biosynthesis, and DNA repair, suggesting a positive impact on gut function.
3. Hormonal and Inflammatory Biomarkers
- White blood cell leptin expression was significantly higher in dogs receiving probiotics compared to both the postbiotic and control groups. While the clinical implications of this finding are still unclear, leptin is known to play a role in energy balance and immune function.
- No significant differences were observed in glycemic or insulinemic responses across groups, indicating that neither probiotics nor postbiotics affected glucose metabolism.
- Inflammatory biomarkers, serum metabolites, and complete blood counts remained within normal ranges for all dogs, underscoring the safety of the supplements.
Because heat-treated BPL1 has a similar effect to live BPL1 in healthy adult dogs, pet product formulators will have greater flexibility through the manufacturing and supply process, as they don’t need to make adaptations for living microorganisms. Notably, extreme heat from extrusion and baking common in pet food processing can diminish the efficacy of live probiotics. As inanimate microorganisms, postbiotics can confer a health benefit on the host despite these challenging conditions.


















